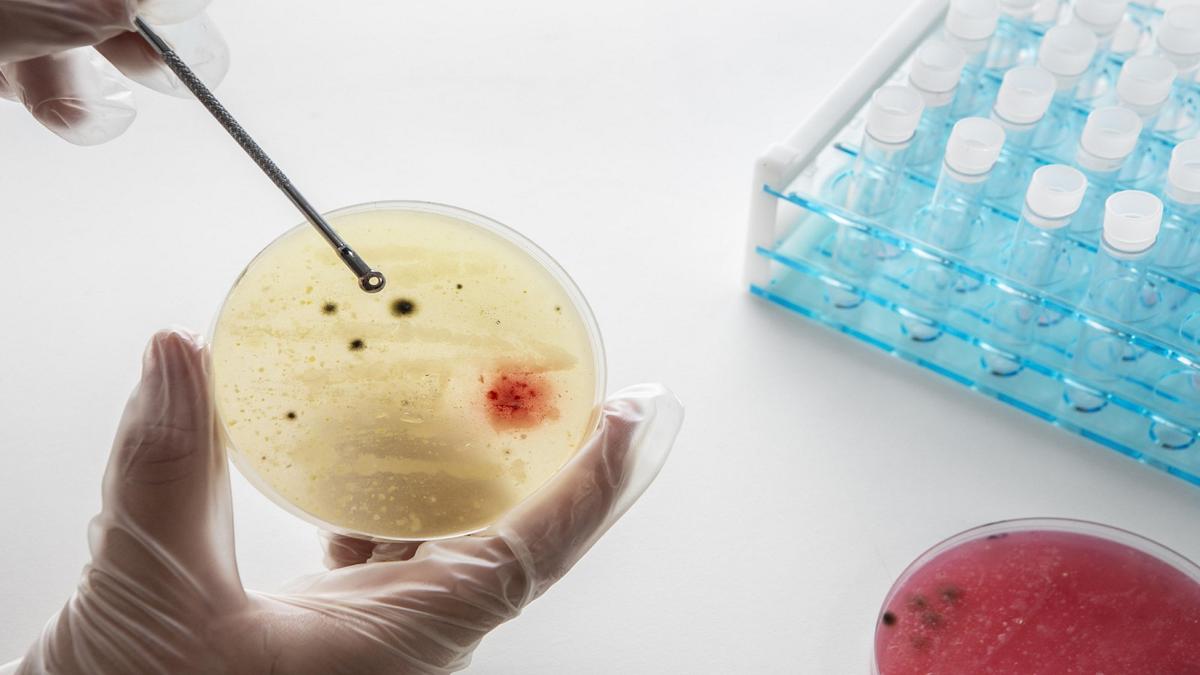
IIT Bombay researchers use microbes to unlock nature’s hidden rules

एक सफलता में जो जीव विज्ञान के सबसे गूढ़ सवालों में से एक पर नई रोशनी डालती है, IIT-BOMBAY के शोधकर्ताओं ने दिखाया है कि पोषक तत्वों को कैसे प्रस्तुत किया जाता है, में सूक्ष्म अंतर पूरी तरह से रोगाणुओं को धक्का दे सकते हैं विभिन्न विकासवादी पथ।
निष्कर्षों को दो पत्रों में प्रकाशित किया गया था एनपीजे सिस्टम बायोलॉजी एंड एप्लिकेशन और बीएमसी इकोलॉजी एंड इवोल्यूशन।
सुप्रीत सैनी के नेतृत्व में प्रयोगों ने रोगाणुओं पर ध्यान केंद्रित किया इशरीकिया कोलीएक सामान्य आंत जीवाणु, और सक्षयताएक प्रकार का खमीर व्यापक रूप से बेकिंग में उपयोग किया जाता है।
शोधकर्ताओं ने यह परीक्षण करने के लिए अध्ययन किया कि क्या रोगाणुओं को इस बात की परवाह है कि वे क्या खाते हैं और साथ ही यह कैसे परोसा जाता है। उन्होंने रासायनिक रूप से संबंधित शर्करा ग्लूकोज और गैलेक्टोज का उपयोग किया लेकिन उन्हें अलग तरीके से पैक किया। रोगाणुओं के एक समूह को दोनों का एक सरल मिश्रण मिला, जबकि अन्य को लैक्टोज या मेलिबियोस खिलाया गया, एक ही घटकों से बने जटिल शर्करा लेकिन अलग -अलग बंधे हुए।
“हमने शर्करा को चुना है जो रासायनिक रूप से संबंधित हैं। हमारा लक्ष्य यह देखना था कि क्या रोगाणुओं की परवाह है कि भोजन कैसे परोसा जाता है,” प्रो। सैनी ने कहा।
300 से अधिक पीढ़ियों, रोगाणुओं को अलग -अलग रास्तों के साथ विकसित किया गया। में ई कोलाईएक समूह तेजी से बढ़ता गया जबकि दूसरे ने अधिक बायोमास का उत्पादन किया। खमीर आबादी समान रूप से भिन्न थी। आनुवंशिक अध्ययनों से पता चला कि कई उत्परिवर्तन ने इन अनुकूलन में योगदान दिया।
पोस्टडॉक्टोरल विद्वान और दोनों अध्ययनों के लेखक नेतिका अहलावाट ने कहा, “हम इन सूक्ष्म मतभेदों की उम्मीद नहीं करते थे कि वे पूरी तरह से अलग -अलग अनुकूली पथ बना सकें।” “निष्कर्ष बताते हैं कि जिस तरह से एक कोशिका एक पोषक तत्वों पर प्रतिक्रिया करती है, वह प्रभावित कर सकती है कि कौन से उत्परिवर्तन फायदेमंद हैं और क्या रास्ते विकास ले सकते हैं।”

जब शोधकर्ताओं ने दोनों की इन विकसित आबादी को स्थानांतरित कर दिया ई कोलाई और नए चीनी वातावरण में खमीर, उनके विकास ने एक पैटर्न का पालन किया। यह घटना, जिसे एक प्लियोट्रोपिक प्रतिक्रिया कहा जाता है, एक वातावरण में अनुकूलन के दुष्प्रभावों को दूसरे में व्यवहार को प्रभावित करने के लिए संदर्भित करता है।
“यह एक अच्छा अनुस्मारक है कि विकास लचीला और विवश दोनों है,” पाविथ्रा वेंकटारामन ने कहा, आईआईटी-बम्बे में एक पूर्व पीएचडी छात्र और के एक लेखक ई। कोलाई अध्ययन। “समान वातावरण में, परिणाम अप्रत्याशित था, विकास में एक संभावित लचीलेपन का प्रदर्शन करते हुए। हालांकि, नए वातावरण में उस विकास के फुफ्फुसीय दुष्प्रभाव आश्चर्यजनक रूप से सुसंगत थे। एक विकसित आबादी ने कहीं और प्रदर्शन किया, इस आधार पर भविष्यवाणी की जा सकती है कि उसके पूर्वजों ने कैसे व्यवहार किया था।”
निहितार्थ अकादमिक हित से परे हैं। पोषक तत्वों के संयोजन को सावधानीपूर्वक ट्विक करके, शोधकर्ताओं को उन उपभेदों को बनाने के लिए माइक्रोबियल विकास को निर्देशित करने में सक्षम हो सकता है जो तेजी से बढ़ते हैं या अधिक कुशल होते हैं, भोजन और पेय पदार्थों, फार्मास्यूटिकल्स और बायोफ्यूल में अनुप्रयोगों के लिए दरवाजे खोलते हैं। अध्ययन में रोगजनकों के लिए उपलब्ध विकासवादी मार्गों को प्रतिबंधित करके एंटीबायोटिक प्रतिरोध से लड़ने की रणनीति का भी सुझाव दिया गया है।
“हम रोगजनकों के लिए उपलब्ध विकासवादी रास्तों को सीमित करने के लिए संसाधनों का उपयोग करने की कल्पना कर सकते हैं, जिससे यह एंटीबायोटिक प्रतिरोध के लिए कठिन हो जाता है,” प्रो। सैनी ने कहा। “यह अभी भी शुरुआती दिन है, लेकिन संभावना रोमांचक है।”
कई संभावित अंत के साथ एक विज्ञान कथा कहानी की तरह, विकास एक ही शुरुआती बिंदु से शुरू होता है, लेकिन अंतहीन तरीकों से प्रकट हो सकता है। IIT-BOMBAY अध्ययनों से पता चला है कि जबकि यात्रा अप्रत्याशित हो सकती है, अनुकूलन के पीछे छिपे हुए नियमों को समझने से हमें यह अनुमान लगाने की अनुमति मिल सकती है कि विकास अंततः कहां हो सकता है।
purnima.sah@thehindu.co.in